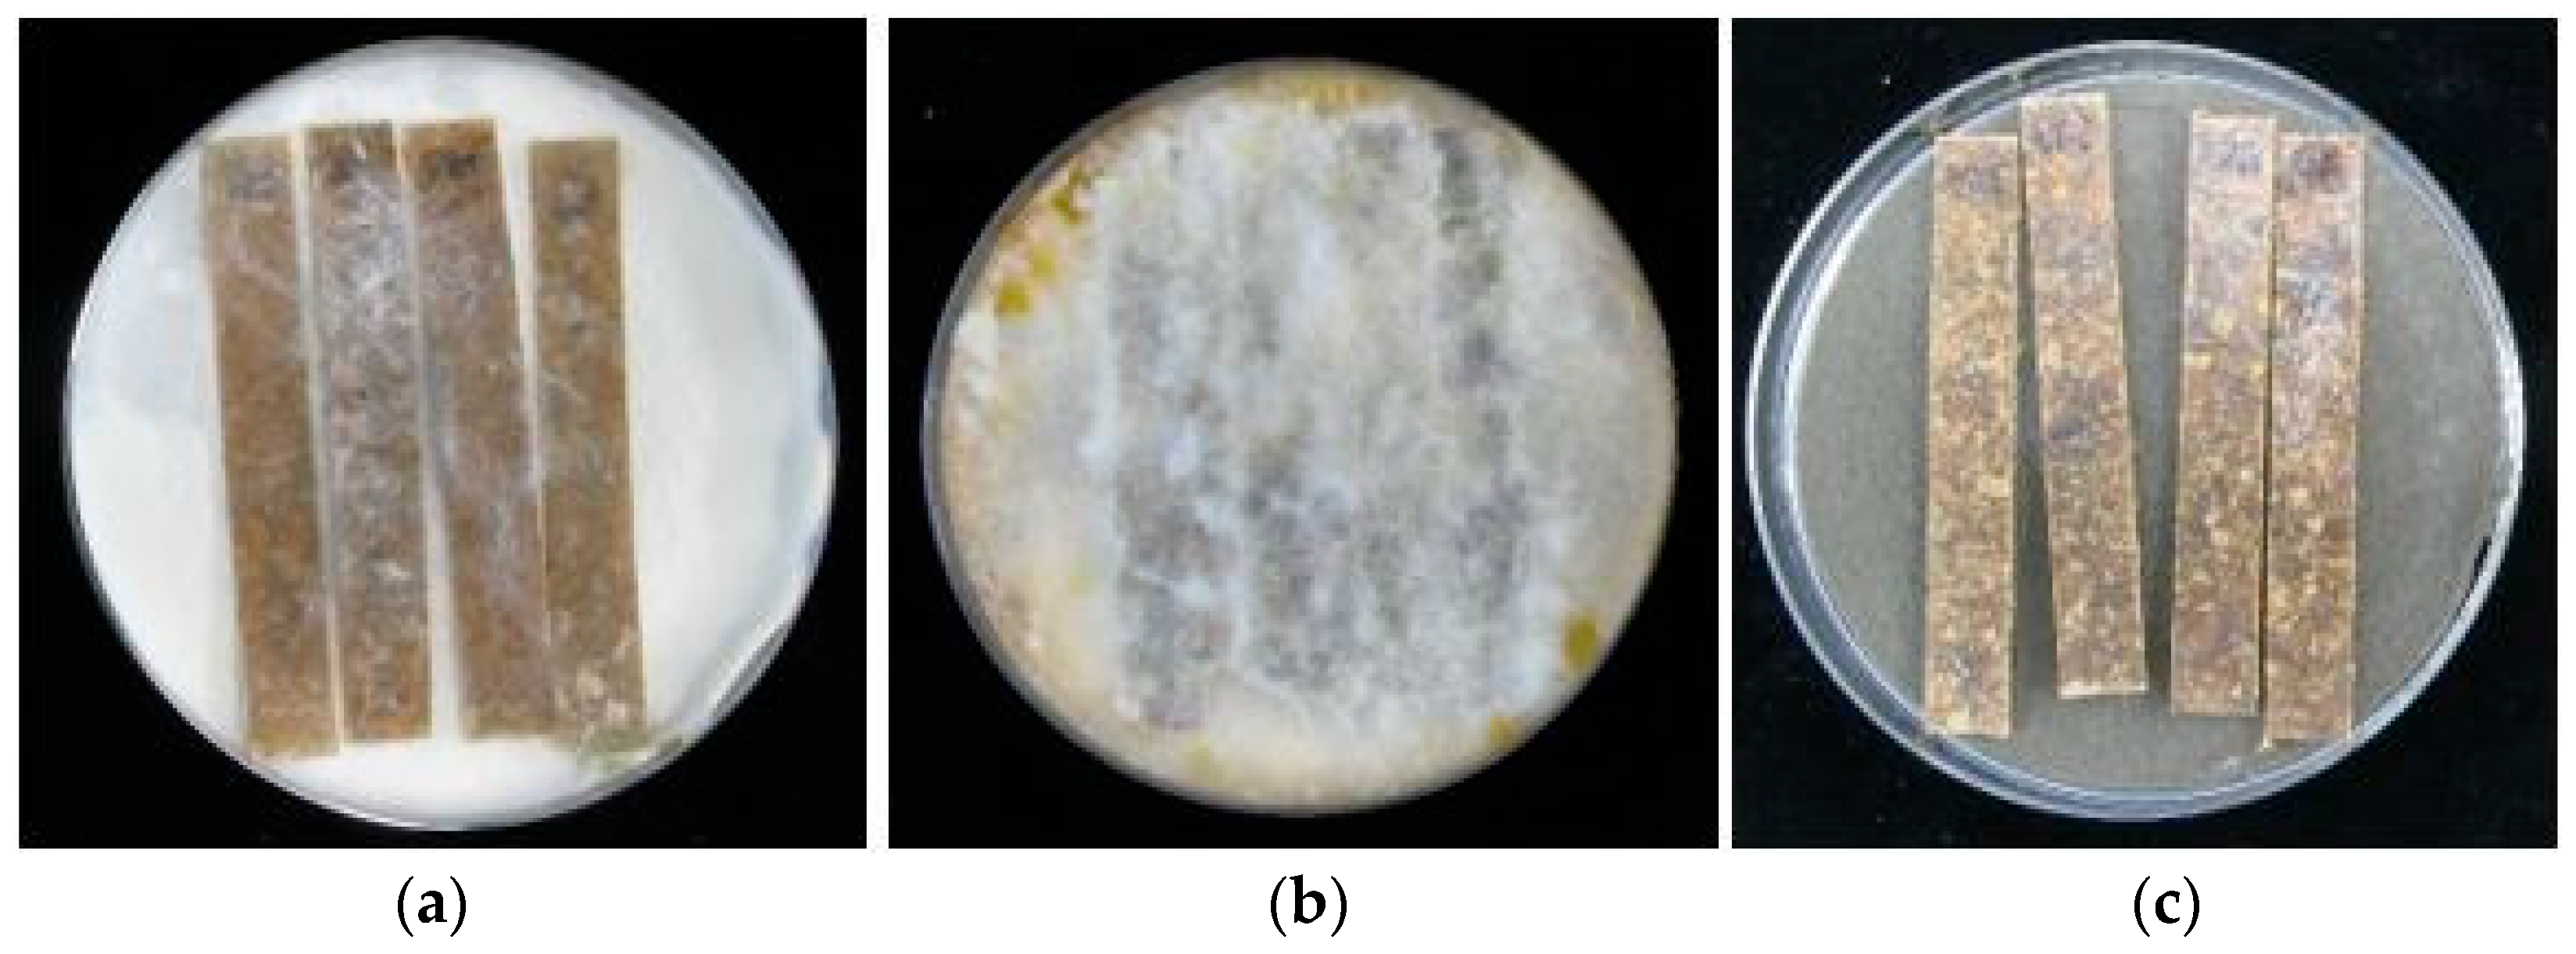
Materials 15 03435 g005 Materials 15 03435 g005

Bioactive Propolis-Silane System as Antifungal Agent in Lignocellulosic-Polymer Composites
Abstract
1. Introduction
2. Materials and Methods
2.1. Materials
2.2. Wood Treatment
2.3. Preparation of Composite Materials
2.4. UV Aging Tests of Composites Materials
- The dry cycle lasted 8 h, during which the samples were exposed to radiation of the intensity of 0.76 W/m2, wavelength of l = 340 nm, and temperature of 60 °C, under the conditions of forced air circulation.
- The wet cycle lasted 4 h, during which the samples were exposed to steam, at 50 °C, with the fluorescent lamp turned off and under the conditions of forced air circulation.
2.5. Biological Resistance of Composite Materials
2.6. Characterization of Polymer Composites
2.6.1. Attenuated Total Reflectance–Fourier Transform Infrared Spectroscopy (ATR–FTIR)
2.6.2. X-ray Powder Diffraction (XRD)
2.6.3. Mechanical Tests
3. Results and Discussion
3.1. Weight Loss of Composites Caused by Wood-Decaying Fungi
3.2. Changes in Composite Structure Caused by Decay Fungi
3.3. Supermolecular Structure of Polymer Composites after UV Aging and Biological Action
3.4. Mechanical Testing of Polymer Composites after UV Aging and Biological Action
4. Conclusions
Supplementary Materials
Author Contributions
Funding
Institutional Review Board Statement
Informed Consent Statement
Data Availability Statement
Conflicts of Interest
References
- Thomas, S.; Visakh, P.M.; Mathew, A.P. Advances in Natural Polymers: Composites and Nanocomposites; Springer: Berlin/Heidelberg, Germany, 2012; Volume 18, ISBN 9783642209406. [Google Scholar]
- Sandberg, D.; Kutnar, A.; Mantanis, G. Wood Modification Technologies—A Review. iForest Biogeosci. For. 2017, 10, 895–908. [Google Scholar] [CrossRef]
- Jiménez, A.; Peltzer, M.A.; Ruseckaite, R.A. Poly(Lactic Acid) Science and Technology: Processing, Properties, Additives and Applications; Royal Society of Chemistry: London, UK, 2015; ISBN 978-1-84973-879-8. [Google Scholar]
- Arwinfar, F.; Hosseinihashemi, S.K.; Latibari, A.J.; Lashgari, A.; Ayrilmis, N. Mechanical Properties and Morphology of Wood Plastic Composites Produced with Thermally Treated Beech Wood. BioResources 2016, 11, 1494–1504. [Google Scholar] [CrossRef][Green Version]
- Bledzki, A.K.; Faruk, O.; Huque, M. Physico-Mechanical Studies of Wood Fiber Reinforced Composites. Polym. Plast. Technol. Eng. 2002, 41, 435–451. [Google Scholar] [CrossRef]
- Nuñez, A.J.; Sturm, P.C.; Kenny, J.M.; Aranguren, M.I.; Marcovich, N.E.; Reboredo, M.M. Mechanical Characterization of Polypropylene-Wood Flour Composites. J. Appl. Polym. Sci. 2003, 88, 1420–1428. [Google Scholar] [CrossRef]
- Włodarczyk-Fligier, A.; Polok-Rubiniec, M. Studies of Resistance of PP/Natural Filler Polymer Composites to Decomposition Caused by Fungi. Materials 2021, 14, 1368. [Google Scholar] [CrossRef]
- Avérous, L.; Le Digabel, F. Properties of Biocomposites Based on Lignocellulosic Fillers. Carbohydr. Polym. 2006, 66, 480–493. [Google Scholar] [CrossRef]
- Alan, K.T.L.; Hung, A.P.Y. Natural Fiber-Reinforced Biodegradable and Bioresorbable Polymer Composites; Elsevier: Amsterdam, The Netherlands, 2017; ISBN 9780081006696. [Google Scholar]
- Bendjaouahdou, C.; Bensaad, S. Aging Studies of a Polypropylene and Natural Rubber Blend. Int. J. Ind. Chem. 2018, 9, 345–352. [Google Scholar] [CrossRef]
- Ashori, A. Wood–Plastic Composites as Promising Green-Composites for Automotive Industries! Bioresour. Technol. 2008, 99, 4661–4667. [Google Scholar] [CrossRef]
- Thakur, V.K.; Thakur, M.K. Processing and Characterization of Natural Cellulose Fibers/Thermoset Polymer Composites. Carbohydr. Polym. 2014, 109, 102–117. [Google Scholar] [CrossRef]
- Wu, J.; Yu, D.; Chan, C.M.; Kim, J.; Mai, Y.W. Effect of Fiber Pretreatment Condition on the Interfacial Strength and Mechanical Properties of Wood Fiber/PP Composites. J. Appl. Polym. Sci. 2000, 76, 1000–1010. [Google Scholar] [CrossRef]
- Dányádi, L.; Móczó, J.; Pukánszky, B. Effect of Various Surface Modifications of Wood Flour on the Properties of PP/Wood Composites. Compos. Part. A Appl. Sci. Manuf. 2010, 41, 199–206. [Google Scholar] [CrossRef]
- Abdulkhani, A.; Hosseinzadeh, J.; Ashori, A.; Dadashi, S.; Takzare, Z. Preparation and Characterization of Modified Cellulose Nanofibers Reinforced Polylactic Acid Nanocomposite. Polym. Test. 2014, 35, 73–79. [Google Scholar] [CrossRef]
- Croitoru, C.; Varodi, A.M.; Timar, M.C.; Roata, I.C.; Stanciu, E.M.; Pascu, A. Wood-Plastic Composites Based on HDPE and Ionic Liquid Additives. J. Mater. Sci. 2018, 53, 4132–4143. [Google Scholar] [CrossRef]
- Sahlin, K.; Forsgren, L.; Moberg, T.; Bernin, D.; Rigdahl, M.; Westman, G. Surface Treatment of Cellulose Nanocrystals (CNC): Effects on Dispersion Rheology. Cellulose 2018, 25, 331–345. [Google Scholar] [CrossRef]
- Schirp, A.; Wolcott, M.P. Influence of Fungal Decay and Moisture Absorption on Mechanical Properties of Extruded Wood-Plastic Composites. Wood Fiber Sci. 2005, 37, 643–652. [Google Scholar]
- Feng, J.; Zhang, H.; He, H.; Huang, X.; Shi, Q. Effects of Fungicides on Mold Resistance and Mechanical Properties of Wood and Bamboo Flour/High-Density Polyethylene Composites. BioResources 2016, 11, 4069–4085. [Google Scholar] [CrossRef]
- Bari, E.; Taghiyari, H.R.; Schmidt, O.; Ghorbani, A.; Aghababaei, H. Effects of Nano-Clay on Biological Resistance of Wood-Plastic Composite against Five Wood-Deteriorating Fungi. Maderas. Cienc. Y Tecnol. 2015, 17, 205–212. [Google Scholar] [CrossRef]
- Rana, A.K.; Thakur, M.K.; Saini, A.K.; Mokhta, S.K.; Moradi, O.; Rydzkowski, T.; Alsanie, W.F.; Wang, Q.; Grammatikos, S.; Thakur, V.K. Recent Developments in Microbial Degradation of Polypropylene: Integrated Approaches towards a Sustainable Environment. Sci. Total Environ. 2022, 826, 154056. [Google Scholar] [CrossRef]
- Krause, K.C.; Brischke, C.; Koddenberg, T.; Buschalsky, A.; Militz, H.; Krause, A. Resistance of Injection Molded Wood-Polypropylene Composites against Basidiomycetes According to En 15534-1: New Insights on the Test Procedure, Structural Alterations, and Impact of Wood Source. Fibers 2019, 7, 92. [Google Scholar] [CrossRef]
- Ashori, A.; Behzad, H.M.; Tarmian, A. Effects of Chemical Preservative Treatments on Durability of Wood Flour/HDPE Composites. Compos. Part. B Eng. 2013, 47, 308–313. [Google Scholar] [CrossRef]
- Feng, J.; Chen, J.; Chen, M.; Su, X.; Shi, Q. Effects of Biocide Treatments on Durability of Wood and Bamboo/High Density Polyethylene Composites against Algal and Fungal Decay. J. Appl. Polym. Sci. 2017, 134, 1–12. [Google Scholar] [CrossRef]
- Pánek, M.; Reinprecht, L.; Hulla, M. Ten Essential Oils for Beech Wood Protection—Efficacy Against Wood-Destroying Fungi and Moulds, and Effect on Wood Discoloration. BioResources 2014, 9, 5588–5603. [Google Scholar] [CrossRef]
- Kwaśniewska-Sip, P.; Cofta, G.; Nowak, P.B. Resistance of Fungal Growth on Scots Pine Treated with Caffeine. Int. Biodeterior. Biodegrad. 2018, 132, 178–184. [Google Scholar] [CrossRef]
- Teacă, C.A.; Roşu, D.; Mustaţă, F.; Rusu, T.; Roşu, L.; Roşca, I.; Varganici, C.D. Natural Bio-Based Products for Wood Coating and Protection against Degradation: A Review. BioResources 2019, 14, 4873–4901. [Google Scholar] [CrossRef]
- Akcay, C.; Birinci, E.; Birinci, C.; Kolayli, S. Durability of Wood Treated with Propolis. BioResources 2020, 15, 1547–1562. [Google Scholar] [CrossRef]
- Fang, S.; Feng, X.; Lei, Y.; Chen, Z.; Yan, L. Improvement of Wood Decay Resistance with Cinnamaldehyde Chitosan Emulsion. Ind. Crops Prod. 2021, 160, 113118. [Google Scholar] [CrossRef]
- Woźniak, M.; Kwaśniewska-Sip, P.; Krueger, M.; Roszyk, E.; Ratajczak, I. Chemical, Biological and Mechanical Characterization of Wood Treated with Propolis Extract and Silicon Compounds. Forests 2020, 11, 907. [Google Scholar] [CrossRef]
- Casado-Sanz, M.M.; Silva-Castro, I.; Ponce-Herrero, L.; Martín-Ramos, P.; Martín-Gil, J.; Acuña-Rello, L. White-Rot Fungi Control on Populus Spp. Wood by Pressure Treatments with Silver Nanoparticles, Chitosan Oligomers and Propolis. Forests 2019, 10, 885. [Google Scholar] [CrossRef]
- Silva-Castro, I.; Diez, J.J.; Martín-Ramos, P.; Pinto, G.; Alves, A.; Martín-Gil, J.; Martín-García, J. Application of Bioactive Coatings Based on Chitosan and Propolis for Pinus Spp. Protection against Fusarium Circinatum. Forests 2018, 9, 685. [Google Scholar] [CrossRef]
- Ratajczak, I.; Woźniak, M.; Kwaśniewska-Sip, P.; Szentner, K.; Cofta, G.; Mazela, B. Chemical Characterization of Wood Treated with a Formulation Based on Propolis, Caffeine and Organosilanes. Eur. J. Wood Wood Prod. 2018, 76, 775–781. [Google Scholar] [CrossRef]
- Woźniak, M.; Mania, P.; Roszyk, E.; Ratajczak, I. Bending Strength of Wood Treated with Propolis Extract and Silicon Compounds. Materials 2021, 14, 819. [Google Scholar] [CrossRef]
- Woźniak, M.; Ratajczak, I.; Lis, B.; Krystofiak, T. Hydrophobic Properties of Wood Traeted with Propolis-Silane Formulations. Wood Res. 2018, 63, 517–524. [Google Scholar]
- Friedrich, D. Comparative Study on Artificial and Natural Weathering of Wood-Polymer Compounds: A Comprehensive Literature Review. Case Stud. Constr. Mater. 2018, 9, e00196. [Google Scholar] [CrossRef]
- Aydemir, D.; Alsan, M.; Can, A.; Altuntas, E.; Sivrikaya, H. Accelerated Weathering and Decay Resistance of Heat-Treated Wood Reinforced Polypropylene Composites. Drv. Ind. 2019, 70, 279–285. [Google Scholar] [CrossRef]
- La Mantia, F.P.; Morreale, M. Accelerated Weathering of Polypropylene/Wood Flour Composites. Polym. Degrad. Stab. 2008, 93, 1252–1258. [Google Scholar] [CrossRef]
- Ibach, R.; Gnatowski, M.; Sun, G.; Glaeser, J.; Leung, M.; Haight, J. Laboratory and Environmental Decay of Wood–Plastic Composite Boards: Flexural Properties. Wood Mater. Sci. Eng. 2018, 13, 81–96. [Google Scholar] [CrossRef]
- Catto, A.L.; Montagna, L.S.; Almeida, S.H.; Silveira, R.M.B.; Santana, R.M.C. Wood Plastic Composites Weathering: Effects of Compatibilization on Biodegradation in Soil and Fungal Decay. Int. Biodeterior. Biodegrad. 2016, 109, 11–22. [Google Scholar] [CrossRef]
- Fabiyi, J.S.; McDonald, A.G.; Wolcott, M.P.; Griffiths, P.R. Wood Plastic Composites Weathering: Visual Appearance and Chemical Changes. Polym. Degrad. Stab. 2008, 93, 1405–1414. [Google Scholar] [CrossRef]
- Gunjal, J.; Aggarwal, P.; Chauhan, S. Changes in Colour and Mechanical Properties of Wood Polypropylene Composites on Natural Weathering. Maderas Cienc. Y Tecnol. 2020, 22, 325–334. [Google Scholar] [CrossRef]
- Kuka, E.; Andersons, B.; Cirule, D.; Andersone, I.; Kajaks, J.; Militz, H.; Bicke, S. Weathering Properties of Wood-Plastic Composites Based on Heat-Treated Wood and Polypropylene. Compos. Part A Appl. Sci. Manuf. 2020, 139, 106102. [Google Scholar] [CrossRef]
- Naumann, A.; Stephan, I.; Noll, M. Material Resistance of Weathered Wood-Plastic Composites against Fungal Decay. Int. Biodeterior. Biodegrad. 2012, 75, 28–35. [Google Scholar] [CrossRef]
- Odalanowska, M.; Woźniak, M.; Ratajczak, I.; Zielińska, D.; Cofta, G.; Borysiak, S. Propolis and Organosilanes as Innovative Hybrid Modifiers in Wood-Based Polymer Composites. Materials 2021, 14, 464. [Google Scholar] [CrossRef]
- Hindeleh, A.M.; Johnson, D.J. The Resolution of Multipeak Data in Fibre Science. J. Phys. D Appl. Phys. 1971, 4, 259–263. [Google Scholar] [CrossRef]
- Rabiej, S. A Comparison of Two X-Ray Diffraction Procedures for Crystallinity Determination. Eur. Polym. J. 1991, 27, 947–954. [Google Scholar] [CrossRef]
- Woźniak, M.; Kwaśniewska-Sip, P.; Waśkiewicz, A.; Cofta, G.; Ratajczak, I. The Possibility of Propolis Extract Application in Wood Protection. Forests 2020, 11, 465. [Google Scholar] [CrossRef]
- Kuka, E.; Cirule, D.; Kajaks, J.; Janberga, A.; Andersone, I.; Andersons, B. Fungal Degradation of Wood Plastic Composites Made with Thermally Modified Wood Residues. Key Eng. Mater. 2017, 721, 8–12. [Google Scholar] [CrossRef]
- Müller, M.; Gellerich, A.; Militz, H.; Krause, A. Resistance of Modified Polyvinyl Chloride/Wood Flour Composites to Basidiomycetes. Eur. J. Wood Wood Prod. 2013, 71, 199–204. [Google Scholar] [CrossRef][Green Version]
- Lis, B.; Woźniak, M.; Krystofiak, T.; Ratajczak, I. Effect of Accelerated Aging on the Color Changes of Wood Treated with Eco-Friendly Formulations Based on Propolis and Sslicon Compounds. BioResources 2020, 15, 3667–3677. [Google Scholar] [CrossRef]
- Schmidt, O. Wood and Tree Fungi: Biology, Damage, Protection and Use; Springer: Berlin/Heidelberg, Germany, 2006; ISBN 978-3-540-32138-5. [Google Scholar]
- Daniel, G. Fungal Degradation of Wood Cell Walls. In Secondary Xylem Biology; Elsevier: Amsterdam, The Netherlands, 2016; pp. 131–167. [Google Scholar]
- Kumar, A.; Pavla, R.; Sever, S.A.; Humar, M.; Pavlič, M.; Jan, T.; Petr, H.; Zigon, J.; Petric, M. Influence of Surface Modification of Wood with Octadecyltrichlorosilane on Its Dimensional Stability and Resistance against Coniophora Puteana and Molds. Cellulose 2016, 23, 3249–3263. [Google Scholar] [CrossRef]
- Pandey, K.K.; Pitman, A.J. FTIR Studies of the Changes in Wood Chemistry Following Decay by Brown-Rot and White-Rot Fungi. Int. Biodeterior. Biodegrad. 2003, 52, 151–160. [Google Scholar] [CrossRef]
- Durmaz, S.; Özgenç, Ö.; Boyaci, I.H.; YIldIz, Ü.C.; Erişir, E. Examination of the Chemical Changes in Spruce Wood Degraded by Brown-Rot Fungi Using FT-IR and FT-Raman Spectroscopy. Vib. Spectrosc. 2016, 85, 202–207. [Google Scholar] [CrossRef]
- Tomak, E.D. Changes in Chemical Composition of Decayed Scots Pine and Beech Wood. Sci. Eng. Compos. Mater. 2014, 21, 589–595. [Google Scholar] [CrossRef]
- Pandey, K.K.; Pitman, A.J. Examination of the Lignin Content in a Softwood and a Hardwood Decayed by a Brown-Rot Fungus with the Acetyl Bromide Method and Fourier Transform Infrared Spectroscopy. J. Polym. Sci. Part A Polym. Chem. 2004, 42, 2340–2346. [Google Scholar] [CrossRef]
- Tomak, E.D.; Topaloglu, E.; Gumuskaya, E.; Yildiz, U.C.; Ay, N. An FT-IR Study of the Changes in Chemical Composition of Bamboo Degraded by Brown-Rot Fungi. Int. Biodeterior. Biodegrad. 2013, 85, 131–138. [Google Scholar] [CrossRef]
- Fackler, K.; Stevanic, J.S.; Ters, T.; Hinterstoisser, B.; Schwanninger, M.; Salmén, L. Localisation and Characterisation of Incipient Brown-Rot Decay within Spruce Wood Cell Walls Using FT-IR Imaging Microscopy. Enzym. Microb. Technol. 2010, 47, 257–267. [Google Scholar] [CrossRef]
- Can, A.; Sivrikaya, H. Chemical Characterization of Fungal Deterioration in Populus Alba by FT-IR Chemical Characterization of Fungal Deterioration in Populus Alba by FT-IR. J. Bartin Fac. For. 2017, 19, 139–147. [Google Scholar]
- Mohebby, B. Attenuated Total Reflection Infrared Spectroscopy of White-Rot Decayed Beech Wood. Int. Biodeterior. Biodegrad. 2005, 55, 247–251. [Google Scholar] [CrossRef]
- Fackler, K.; Stevanic, J.S.; Ters, T.; Hinterstoisser, B.; Schwanninger, M.; Salmén, L. FT-IR Imaging Microscopy to Localise and Characterise Simultaneous and Selective White-Rot Decay within Spruce Wood Cells. Holzforschung 2011, 65, 411–420. [Google Scholar] [CrossRef]
- Akhtari, M.; Taghiyari, H.R.; Kokandeh, M.G. Effect of Some Metal Nanoparticles on the Spectroscopy Analysis of Paulownia Wood Exposed to White-Rot Fungus. Eur. J. Wood Wood Prod. 2013, 71, 283–285. [Google Scholar] [CrossRef]
- Bari, E.; Daryaei, M.G.; Karim, M.; Bahmani, M.; Schmidt, O.; Woodward, S.; Ghanbary, M.A.T.; Sistani, A. Decay of Carpinus Betulus Wood by Trametes Versicolor—An Anatomical and Chemical Study. Int. Biodeterior. Biodegrad. 2019, 137, 68–77. [Google Scholar] [CrossRef]
- Bari, E.; Nazarnezhad, N.; Kazemi, S.M.; Ghanbary, M.A.T.; Mohebby, B.; Schmidt, O.; Clausen, C.A. Comparison between Degradation Capabilities of the White Rot Fungi Pleurotus Ostreatus and Trametes Versicolor in Beech Wood. Int. Biodeterior. Biodegrad. 2015, 104, 231–237. [Google Scholar] [CrossRef]
- Karim, M.; Daryaei, M.G.; Torkaman, J.; Oladi, R.; Ghanbary, M.A.T.; Bari, E.; Yilgor, N. Natural Decomposition of Hornbeam Wood Decayed by the White Rot Fungus Trametes Versicolor. An. Acad. Bras. Cienc. 2017, 89, 2647–2655. [Google Scholar] [CrossRef]
- Popescu, C.M.; Popescu, M.C.; Vasile, C. Characterization of Fungal Degraded Lime Wood by FT-IR and 2D IR Correlation Spectroscopy. Microchem. J. 2010, 95, 377–387. [Google Scholar] [CrossRef]
- Fackler, K.; Schwanninger, M.; Gradinger, C.; Srebotnik, E.; Hinterstoisser, B.; Messner, K. Fungal Decay of Spruce and Beech Wood Assessed by Near-Infrared Spectroscopy in Combination with Uni- and Multivariate Data Analysis. Holzforschung 2007, 61, 680–687. [Google Scholar] [CrossRef]
- Chrissopoulou, K.; Anastasiadis, S.H. Polyolefin/Layered Silicate Nanocomposites with Functional Compatibilizers. Eur. Polym. J. 2011, 47, 600–613. [Google Scholar] [CrossRef]
- Salaita, G.N.; Ma, F.M.S.; Parker, T.C.; Hoflund, G.B. Weathering Properties of Treated Southern Yellow Pine Wood Examined by X-ray Photoelectron Spectroscopy, Scanning Electron Microscopy and Physical Characterization. Appl. Surf. Sci. 2008, 254, 3925–3934. [Google Scholar] [CrossRef]
- Guadagno, L.; Naddeo, C.; Vittoria, V. Structural and Morphological Changes during UV Irradiation of the Crystalline Helical Form of Syndiotactic Polypropylene. Macromolecules 2004, 37, 9826–9834. [Google Scholar] [CrossRef]
- Morancho, J.M.; Ramis, X.; Fernández, X.; Cadenato, A.; Salla, J.M.; Vallés, A.; Contat, L.; Ribes, A. Calorimetric and Thermogravimetric Studies of UV-Irradiated Polypropylene/Starch-Based Materials Aged in Soil. Polym. Degrad. Stab. 2006, 91, 44–51. [Google Scholar] [CrossRef]
- Inagaki, T.; Siesler, H.W.; Mitsui, K.; Tsuchikawa, S. Difference of the Crystal Structure of Cellulose in Wood after Hydrothermal and Aging Degradation: A NIR Spectroscopy and XRD Study. Biomacromolecules 2010, 11, 2300–2305. [Google Scholar] [CrossRef] [PubMed]
- Lionetto, F.; Del Sole, R.; Cannoletta, D.; Vasapollo, G.; Maffezzoli, A. Monitoring Wood Degradation during Weathering by Cellulose Crystallinity. Materials 2012, 5, 1910–1922. [Google Scholar] [CrossRef]
- Couteau, C.; Pommier, M.; Paparis, E.; Coiffard, L.J.M. Photoprotective Activity of Propolis. Nat. Prod. Res. 2008, 22, 264–268. [Google Scholar] [CrossRef]
- Karapetsas, A.; Voulgaridou, G.P.; Konialis, M.; Tsochantaridis, I.; Kynigopoulos, S.; Lambropoulou, M.; Stavropoulou, M.I.; Stathopoulou, K.; Aligiannis, N.; Bozidis, P.; et al. Propolis Extracts Inhibit UV-Induced Photodamage in Human Experimental in Vitro Skin Models. Antioxidants 2019, 8, 125. [Google Scholar] [CrossRef]
- Galeotti, F.; Maccari, F.; Fachini, A.; Volpi, N. Chemical Composition and Antioxidant Activity of Propolis Prepared in Different Forms and in Different Solvents Useful for Finished Products. Foods 2018, 7, 41. [Google Scholar] [CrossRef]
- Afiqah, N.; Zafiah, M.R.A.; Rus, M.; Zulhafiz, M.; Syah, A.S.; Hazwanee, F.; Aida, S.; Afiqah, S.N. Mechanical Properties of Wood Polymer Composites (WPCs) After Prolonged Ultra Violet (UV) Irradiation Exposure. Int. J. Eng. Technol. 2018, 7, 258–260. [Google Scholar]
- Seldén, R.; Nyström, B.; Långström, R. UV Aging of Poly(Propylene)/Wood-Fiber Composites. Polym. Compos. 2004, 25, 543–553. [Google Scholar] [CrossRef]
- Curling, S.F.; Clausen, C.A.; Jerrold, W.E. Relationships Between and Chemical Composition of Wood During Incipient Brown-Rot Decay. For. Prod. J. 2002, 52, 34–39. [Google Scholar]

| Tested Fungus | Composite Samples | I1375/1515 | I1160/1515 | I895/1515 |
|---|---|---|---|---|
| WPC before fungus exposition | PP+W | 20.706 | 5.202 | 2.577 |
| PP+W+EEP | 15.716 | 5.344 | 0.687 | |
| PP+W+EEP+silanes | 12.091 | 3.549 | 1.320 | |
| C. puteana | PP+W | 14.646 | 4.192 | 1.774 |
| PP+W+EEP | 4.369 | 2.243 | 0.430 | |
| PP+W+EEP+silanes | 9.770 | 3.005 | 1.179 | |
| C. versicolor | PP+W | 8.472 | 2.743 | 1.090 |
| PP+W+EEP | 3.887 | 1.813 | 0.481 | |
| PP+W+EEP+silanes | 4.601 | 2.021 | 0.549 | |
| Ch. globosum | PP+W | 7.728 | 2.997 | 1.246 |
| PP+W+EEP | 2.213 | 1.309 | 0.411 | |
| PP+W+EEP+silanes | 4.536 | 2.101 | 0.748 |
| Composite Samples | Xc (%) | |||
|---|---|---|---|---|
| Tested Fungus | ||||
| - | C. puteana | C. verisolor | Ch. globosum | |
| PP+W “0” | 30 | 31 | 28 | 34 |
| PP+W+EEP “0” | 37 | 35 | 37 | 40 |
| PP+W+EEP+silanes “0” | 36 | 38 | 37 | 39 |
| PP+W 30 days | 32 | 41 | 40 | 43 |
| PP+W+EEP 30 days | 40 | 44 | 43 | 43 |
| PP+W+EEP+silanes 30 days | 39 | 38 | 40 | 40 |
| Young’s Modulus (GPa) | ||||||||||||
|---|---|---|---|---|---|---|---|---|---|---|---|---|
| Before Exposure to Fungi | C. puteana (Cp) | C. versicolor (Cv) | Ch. globosum (Chg) | |||||||||
| Time of UV Irradiation (Days) | 0 | 7 | 30 | 0 | 7 | 30 | 0 | 7 | 30 | 0 | 7 | 30 |
| PP+W | 1.42 | 1.42 | 1.12 | 1.42 | 1.34 | 1.20 | 1.44 | 1.31 | 1.15 | 1.32 | 1.22 | 1.15 |
| PP+W+EEP | 1.91 | 1.84 | 1.74 | 1.96 | 1.91 | 1.82 | 1.82 | 1.82 | 1.72 | 1.82 | 1.81 | 1.75 |
| PP+W+EEP+silanes | 1.89 | 1.80 | 1.74 | 2.07 | 1.97 | 1.82 | 1.84 | 1.74 | 1.59 | 1.76 | 1.71 | 1.66 |
| Tensile Strength (MPa) | ||||||||||||
|---|---|---|---|---|---|---|---|---|---|---|---|---|
| Before Exposure to Fungi | C. puteana (Cp) | C. versicolor (Cv) | Ch. globosum (Chg) | |||||||||
| Time of UV Irradiation (Days) | 0 | 7 | 30 | 0 | 7 | 30 | 0 | 7 | 30 | 0 | 7 | 30 |
| PP+W | 13.05 | 13.66 | 10.38 | 12.02 | 12.46 | 10.79 | 15.11 | 12.95 | 10.95 | 12.88 | 13.86 | 10.87 |
| PP+W+EEP | 20.23 | 19.39 | 17.67 | 20.22 | 19.39 | 18.44 | 19.60 | 18.59 | 17.92 | 19.32 | 18.61 | 18.29 |
| PP+W+EEP+silanes | 18.68 | 17.27 | 16.53 | 18.11 | 18.45 | 16.92 | 18.61 | 16.47 | 16.02 | 17.50 | 17.27 | 16.61 |
| Elongation at Break (%) | ||||||||||||
|---|---|---|---|---|---|---|---|---|---|---|---|---|
| Before Exposure to Fungi | C. puteana (Cp) | C. versicolor (Cv) | Ch. globosum (Chg) | |||||||||
| Time of UV Irradiation (Days) | 0 | 7 | 30 | 0 | 7 | 30 | 0 | 7 | 30 | 0 | 7 | 30 |
| PP+W | 1.65 | 1.87 | 1.77 | 1.56 | 1.58 | 1.61 | 2.07 | 2.01 | 1.91 | 1.78 | 1.76 | 1.90 |
| PP+W+EEP | 2.21 | 2.35 | 1.84 | 1.83 | 1.77 | 1.81 | 2.11 | 2.04 | 1.93 | 1.84 | 1.76 | 1.84 |
| PP+W+EEP+silanes | 2.10 | 2.22 | 1.58 | 1.74 | 1.95 | 1.71 | 2.31 | 2.17 | 2.27 | 2.03 | 2.01 | 2.04 |
Publisher’s Note: MDPI stays neutral with regard to jurisdictional claims in published maps and institutional affiliations. |
© 2022 by the authors. Licensee MDPI, Basel, Switzerland. This article is an open access article distributed under the terms and conditions of the Creative Commons Attribution (CC BY) license (https://creativecommons.org/licenses/by/4.0/).
Share and Cite
Odalanowska, M.; Cofta, G.; Woźniak, M.; Ratajczak, I.; Rydzkowski, T.; Borysiak, S. Bioactive Propolis-Silane System as Antifungal Agent in Lignocellulosic-Polymer Composites. Materials 2022, 15, 3435. https://doi.org/10.3390/ma15103435
Odalanowska M, Cofta G, Woźniak M, Ratajczak I, Rydzkowski T, Borysiak S. Bioactive Propolis-Silane System as Antifungal Agent in Lignocellulosic-Polymer Composites. Materials. 2022; 15(10):3435. https://doi.org/10.3390/ma15103435
Chicago/Turabian StyleOdalanowska, Majka, Grzegorz Cofta, Magdalena Woźniak, Izabela Ratajczak, Tomasz Rydzkowski, and Sławomir Borysiak. 2022. "Bioactive Propolis-Silane System as Antifungal Agent in Lignocellulosic-Polymer Composites" Materials 15, no. 10: 3435. https://doi.org/10.3390/ma15103435
APA StyleOdalanowska, M., Cofta, G., Woźniak, M., Ratajczak, I., Rydzkowski, T., & Borysiak, S. (2022). Bioactive Propolis-Silane System as Antifungal Agent in Lignocellulosic-Polymer Composites. Materials, 15(10), 3435. https://doi.org/10.3390/ma15103435









